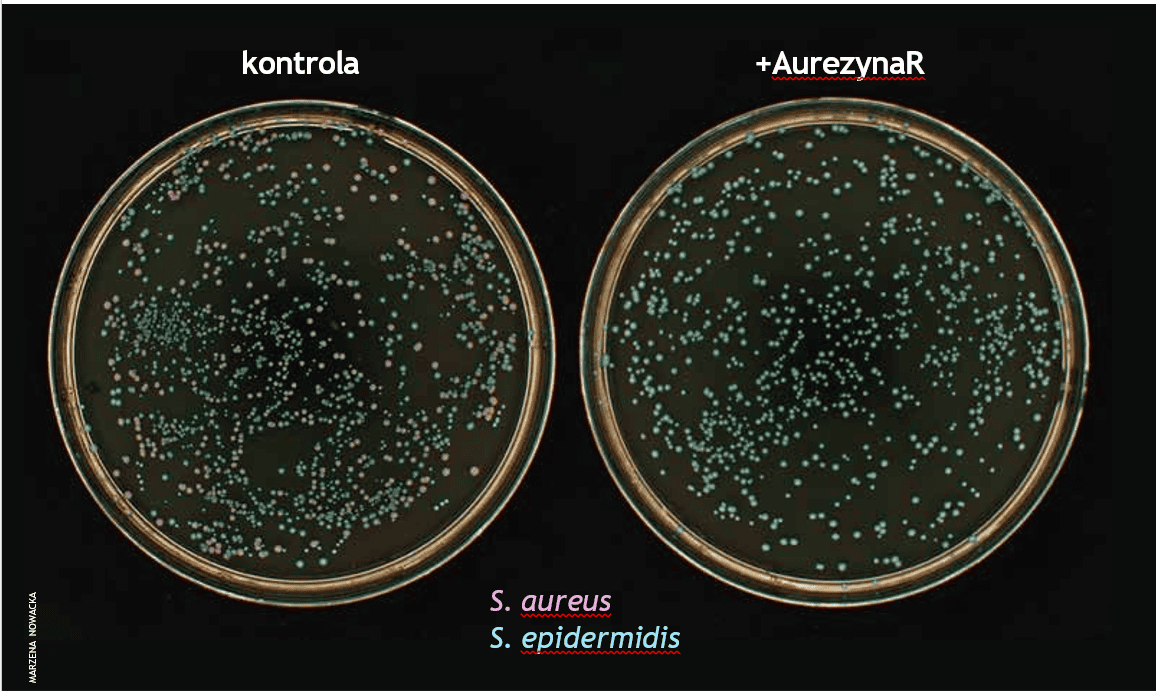

Medycyna
Mikroorganizmy na naszej skórze tworzą swoje mikroświaty, żyjąc z nami w symbiozie.
Skóra człowieka, choć tworzy barierę oddzielającą nasz organizm od środowiska i jego szkodliwych czynników, umożliwia ciągły intensywny z nim kontakt przez zakończenia nerwowe. Ma przy tym bardzo złożoną, niejednorodną powierzchnię, dochodzącą do dwóch metrów kwadratowych. Choć na pierwszy rzut oka wydaje się pustynią, gdy przyjrzymy się jej pod mikroskopem, jest zasiedlona przez miliony mikroorganizmów takich jak bakterie, wirusy i grzyby. Jeśli weźmiemy pod uwagę powierzchnię skóry wokół mieszków włosowych czy gruczołów potowych, to otrzymamy nawet 25-30 m2 siedliska gotowego do zamieszkania. Naskórek na powierzchni skóry jest na ogół chłodny, kwaśny i suchy, ale jego grubość jest zmienna przez zagłębienia, fałdy, mieszki włosowe i gruczoły potowe. To sprawia, że na powierzchni ciała powstają odrębne nisze, w których zamieszkują różne gatunki mikroorganizmów, tworząc unikatową społeczność, zwaną mikrobiotą. Skład jakościowy i ilościowy tej społeczności zależy nie tylko od lokalnych warunków panujących na danym obszarze skóry, lecz także od osobniczych cech gospodarza, włączając wiek, zamieszkiwaną strefę klimatyczną, rodzaj skóry, płeć, kondycję układu odpornościowego, dietę czy wagę ciała. Mikrobiota dwóch różnych osób będzie różna i wyjątkowa, co więcej – jej skład zmienia się w trakcie rozwoju człowieka od noworodka do wieku dorosłego, kiedy staje się stała i stabilna. Kolonizacja sterylnej skóry płodu następuje po raz pierwszy w czasie porodu i mikrobiota u dzieci rozwija się, wchodząc w interakcje z układem immunologicznym. W okresie dojrzewania zmiany w produkcji sebum faworyzują bakterie lipofilowe, z kolei starzejąca się skóra, tracąca możliwość szybkiej regeneracji oraz z wyraźnie cieńszą warstwą naskórka przyczynia się do zmiany składu mikrobioty, co zwiększa ryzyko infekcji.
W wymazach pobranych ze skóry zdrowych dorosłych osób wykrywa się nawet kilka milionów komórek bakteryjnych na każdym centymetrze kwadratowym. Dominują wśród nich gatunki z rodzaju Corynebacterium, Cutibacterium, Micrococcus, Staphylococcus, Streptococcus. Obszary skóry o największej ilości produkowanego przez gruczoły łojowe sebum, np. czoło, fałd uszny, fałd małżowiny tylnej (za uchem) i plecy, wykazują najniższą różnorodność gatunkową mikroorganizmów, są zasiedlane głównie przez bakterie z rodzaju Cutibacterium. Z kolei miejsca wilgotne, takie jak okolica pachowa, wewnętrzna okolica łokciowa i fałd pachwinowy, są skolonizowane głównie przez gronkowce (Staphylococcus) i maczugowce (Corynebacterium). Najbardziej zróżnicowanymi mikrobiologicznie miejscami na skórze są obszary suche, tj. górna część kończyn (np. ręka, ramię, udo), w których głównie identyfikuje się bakterie z gromad Actinobacteria, Proteobacteria, Firmicutes i Bacteriodetes.

Mikroświat na skórze jest zatem tworzony przez bardzo zróżnicowaną grupę bakterii współistniejących w tej samej niszy ekologicznej i współżyjących w pewnej równowadze. Mechanizmy rządzące tym światem są różne, od naturalnej selekcji wymuszonej warunkami panującymi na różnych obszarach skóry, przez konkurencję o zasoby naturalne dostępne w danej niszy, po czynną broń stosowaną przez jedne gatunki bakterii do eliminowania innych. W arsenale „uzbrojenia” mikrobów znajdują się przede wszystkim bakteriocyny, białka lub peptydy o właściwościach bakteriobójczych, które odpowiednio lizują ściany komórkowe konkurenta lub niszczą jego błonę komórkową. Zazwyczaj broń jest zaprojektowana tak, by selektywnie niszczyć konkretny gatunek, co zapewnia precyzyjną kontrolę składu mikrobioty.
Zdrowa skóra
Mikroorganizmy zasiedlające naszą skórę nie powinny być traktowane jak pasażerowie na gapę czy intruzi, ale raczej jako sąsiedzi tworzący z nami jedną wspólnotę.
Biorą one czynny udział w utrzymaniu homeostazy skóry i jej funkcji jako bariery immunologicznej przez m.in. sekrecję proteaz, lipaz, ureaz czy kwasów tłuszczowych, które wpływają na odnawianie warstwy rogowej naskórka oraz utrzymanie stałego pH skóry. Chronią nas również przed kolonizacją bakteriami patogennymi.
Współpraca między mikrobiotą, komórkami skóry i układem immunologicznym gwarantuje utrzymanie jej w dobrej kondycji. Ale jak nasz organizm odróżnia „dobre” bakterie od „złych”? Otóż układ immunologiczny uczy się je rozpoznawać we wczesnym wieku niemowlęcym za pośrednictwem limfocytów T, tolerując np. Staphylococcus epidermidis, gronkowca skórnego, a zwalczając Staphylococcus aureus, gronkowca złocistego, bakterię patogenną. S. epidermidis przez specyficzne elementy na swojej ścianie komórkowej (np. kwasy tejchojowe) lub wydzielane substancje jest wykrywany przez nasz układ immunologiczny, co wyzwala kolejne kaskady sygnałowe w komórkach skóry, które z jednej strony pozwalają na zasiedlenie się tej bakterii na skórze bez wywoływania stanu zapalnego, a z drugiej uniemożliwiają kolonizację jej przez inne gatunki, np. gronkowca złocistego. Co więcej, komórki S. epidermidis alarmują wrodzony układ immunologiczny gospodarza o obecności gronkowca złocistego, uruchamiając jego odpowiedź bakteriobójczą, tj. wytwarzanie peptydów antybakteryjnych. Sam S. epidermidis dodatkowo produkuje bakteriocyny, eliminując patogeny ze skóry, w tym także paciorkowce (Streptococci). Inne komensalne gatunki gronkowców, m.in. Staphylococcus capitis, S. hominis czy S. lugdunensis mogą także wydzielać bakteriobójcze peptydy.

Oprócz obrony gospodarza przed infekcją S. epidermidis wspomaga także utrzymanie bariery ochronnej skóry przez rozkład sfingomieliny, wchodzącej w skład błon komórkowych komórek skóry, do ceramidu, zapobiegając utracie wody. W ostatnich latach dzięki rozwojowi metod molekularnych identyfikacja bakterii w pobranych wymazach skóry stała się szybsza i bardziej precyzyjna. Amplifikacja i sekwencjonowanie konserwowanego genu rybosomalnego 16S rRNA umożliwia identyfikację mikroorganizmów z dokładnością do rzędu. Z kolei szybki rozwój metod sekwencjonowania całych genomów pozwala na przypisanie bakterii z dokładnością do gatunku, a nawet szczepu oraz określenie sekwencji wszystkich genomów mikrobioty (mikrobiomu). Coraz więcej pojawiających się danych o mikrobiomach pozwala na dokładniejsze porównanie ekosystemów skórnych między ludźmi, ich zmienność w czasie i rozwoju. Analizy te pomagają w poznawaniu mechanizmów powstawania konkretnych stanów patologicznych oraz w opracowywaniu nowych, precyzyjnych i skutecznych metod leczenia chorób skóry, w których jedną z przyczyn lub objawów jest zaburzenie składu mikrobioty.
Brak równowagi
Zachwianie równowagi w składzie mikrobioty skóry, tzw. dysbioza, towarzyszy stanom chorobowym, takim jak atopowe zapalenie skóry (AZS), łuszczyca, liszajec, a nawet problemy z gojeniem się ran. Skład mikrobioty skóry u pacjentów z AZS może się zmieniać w różnych stadiach nasilenia choroby, ale ogólnie obserwuje się znaczne zubożenie różnorodności gatunkowej wśród wykrywanych mikroorganizmów z jednoczesną nadreprezentacją gronkowca złocistego. Co ciekawe, obecność gatunków komensalnych (S. epidermidis i S. cohnii) u dzieci do drugiego miesiąca życia obniża prawdopodobieństwo wystąpienia AZS w późniejszym wieku, potwierdzając ich działanie ochronne. W czasie nasilenia objawów AZS obserwuje się wzrost liczby wykrywanych komórek bakterii S. aureus na skórze 90 proc. pacjentów. Gronkowce wydzielają tzw. alfatoksyny lizujące komórki naskórka, a także proteazy powodujące niszczenie połączeń między tymi komórkami oraz aktywację limfocytów T, co pogłębia stan zapalny. Zjawiska te prowadzą do dalszego niszczenia bariery ochronnej skóry, utratę wody i ekspozycję skóry na zewnętrzne czynniki środowiska.
Obecnie dostępne leczenie antybakteryjne jest zwykle oparte na środkach bakteriobójczych o szerokim spektrum działania, takich jak chlorheksydyna. W związku z tym, że są one niespecyficzne, usuwają nie tylko gronkowca złocistego, lecz także pozostałe bakterie ze skóry. Aplikacja antybiotyków, np. mupirocyny czy kwasu fusydowego, oprócz upośledzenia całej mikroflory dodatkowo zwiększa ryzyko rozwoju oporności gronkowca złocistego na antybiotyk, która może rozprzestrzenić się na całą populację, także wśród innych gatunków bakterii. 94 proc. szczepów
S. aureus wyizolowanych od pacjentów z AZS, którzy przez trzy miesiące stosowali terapię kwasem fusydowym, było opornych na ten związek. Dlatego współczesne leczenie AZS skupia się głównie na: i) łagodzeniu objawów stanu zapalnego przez stosowanie sterydów, cyklosporyny, ii) blokowaniu szlaku sygnałowego interleukiny 13 oraz iii) nawilżaniu i zmiękczaniu skóry, by odtworzyć jej naturalną barierę ochronną, a ostatnio także na iv) przywracaniu prawidłowego składu mikrobioty.
Nowoczesne terapie
Wśród wielu innowacyjnych – wciąż jednak pozostających w sferze badań – sposobów walki z nadmierną kolonizacją gronkowca złocistego na skórze pacjentów z AZS jest wykorzystanie naturalnych jego konkurentów – bakterii komensalnych wchodzących w skład prawidłowej mikrobioty. Gronkowce, takie jak S. epi- dermidis, S. hominis, S. warneri lub S. capitis, pobrane ze zdrowych fragmentów skóry pacjentów z AZS, następnie namnożone i aplikowane na podrażnione obszary skóry tych samych osób (autoprzeszczep mikrobioty), powodowały redukcję liczby komórek gronkowca złocistego o 99 proc. Podobne efekty były widoczne w wyniku przeszczepienia bakterii Gram-ujemnych Roseomonas mucosa od zdrowych dawców na skórę atopową lub modulowania składu mikrobioty przez aplikację tzw. prebiotyków, probiotyków i postbiotyków.
Od jakiegoś czasu trwają prace badawcze nad celowanymi terapiami antybakteryjnymi, wybiórczo eliminującymi szczepy S. aureus. Najlepszymi kandydatami na tak selektywne środki są enzybiotyki, czyli enzymy, które rozpoznają fragmenty ściany komórkowej charakterystyczne dla gronkowca złocistego, dzięki czemu lizują tylko ten gatunek bakterii, nie szkodząc pozostałym drobnoustrojom tworzącym mikrobiotę. Takie selektywne usunięcie jednego patogenu pozwala na odbudowę równowagi mikrobioty, wzrost bakterii komensalnych i przywrócenie naturalnej bariery ochronnej skóry, a więc powolny powrót do zdrowia. Co ważne, enzymy te są bezpieczne dla ludzi, zwierząt i środowiska. Ponadto w obliczu rosnącego problemu antybiotykooporności, z którym boryka się współczesna medycyna, enzybiotyki są postrzegane jako substancje antybakteryjne nowej generacji, które nie indukując oporności w takim stopniu jak antybiotyki, dają nadzieję na uniknięcie katastrofy braku środków terapeutycznych na wiele infekcji.
Mimo wielu badań na całym świecie nad enzymami bakteriolitycznymi większość z tych technologii nie wyszła poza zaprezentowanie swojej skuteczności in vivo na modelach zwierzęcych. Dostępny na rynku jedyny białkowy produkt, który może modulować mikrobiotę skóry, to Staphefekt, zarejestrowany jako dermokosmetyk linii Gladskin. Wykazano, że efektywnie eliminuje komórki gronkowca złocistego, ale nie gronkowca skórnego, a dalsze badania tego enzybiotyku weszły w fazę badań klinicznych.
Mikroorganizmy zasiedlające naszą skórę nie powinny być traktowane jak pasażerowie na gapę czy intruzi, ale raczej jako sąsiedzi tworzący z nami jedną wspólnotę.
Nasz zespół już od lat pracuje nad enzybiotykmi, które selektywnie eliminują bakterie patogenne. Wśród nich są także enzybiotyki przeciwko gronkowcowi złocistemu, które jednocześnie są bezpieczne dla bakterii budujących naturalną mikroflorę skóry. Opatentowana przez nas AurezynaR* usuwa S. aureus i jest zupełnie nieszkodliwa dla komensalnych bakterii, takich jak S. epidermidis. Co więcej, enzybiotyk ten jest konkurencyjny w stosunku do Staphefektu dzięki swojej wyjątkowej efektywności i szybkości działania. Dlatego kontynuujemy badania nad wykazaniem skuteczności AurezynyR na pacjentach z atopowym zapaleniem skóry, łuszczycą, liszajcem oraz innymi schorzeniami z nadzieją, że nasz enzybiotyk wkrótce przyniesie ulgę pacjentom.
*PL243304 – hydrolaza peptydoglikanowa, kompozycje ją obejmujące, jej zastosowania oraz sposób hydrolizy ją wykorzystujący.
Chcesz wiedzieć więcej?
Byrd A., Belkaid Y., Segre J., The human skin microbiome, „Nature Reviews Microbiology” 16/2018, doi.org/10.1038/ nrmicro.2017.157
Zhu Y., Yu X., Cheng G., Human skin bacterial microbiota homeostasis: A delicate balance between health and disease, „mLife” 2023, vol. 2(2), doi.org/10.1002/mlf2.12064
Swaney M.H., Kalan L.R., Living in Your Skin: Microbes, Molecules, and Mechanisms, „Infection and Immunity” 2021, vol. 89(10), doi.org/10.1128/iai.00695-20

